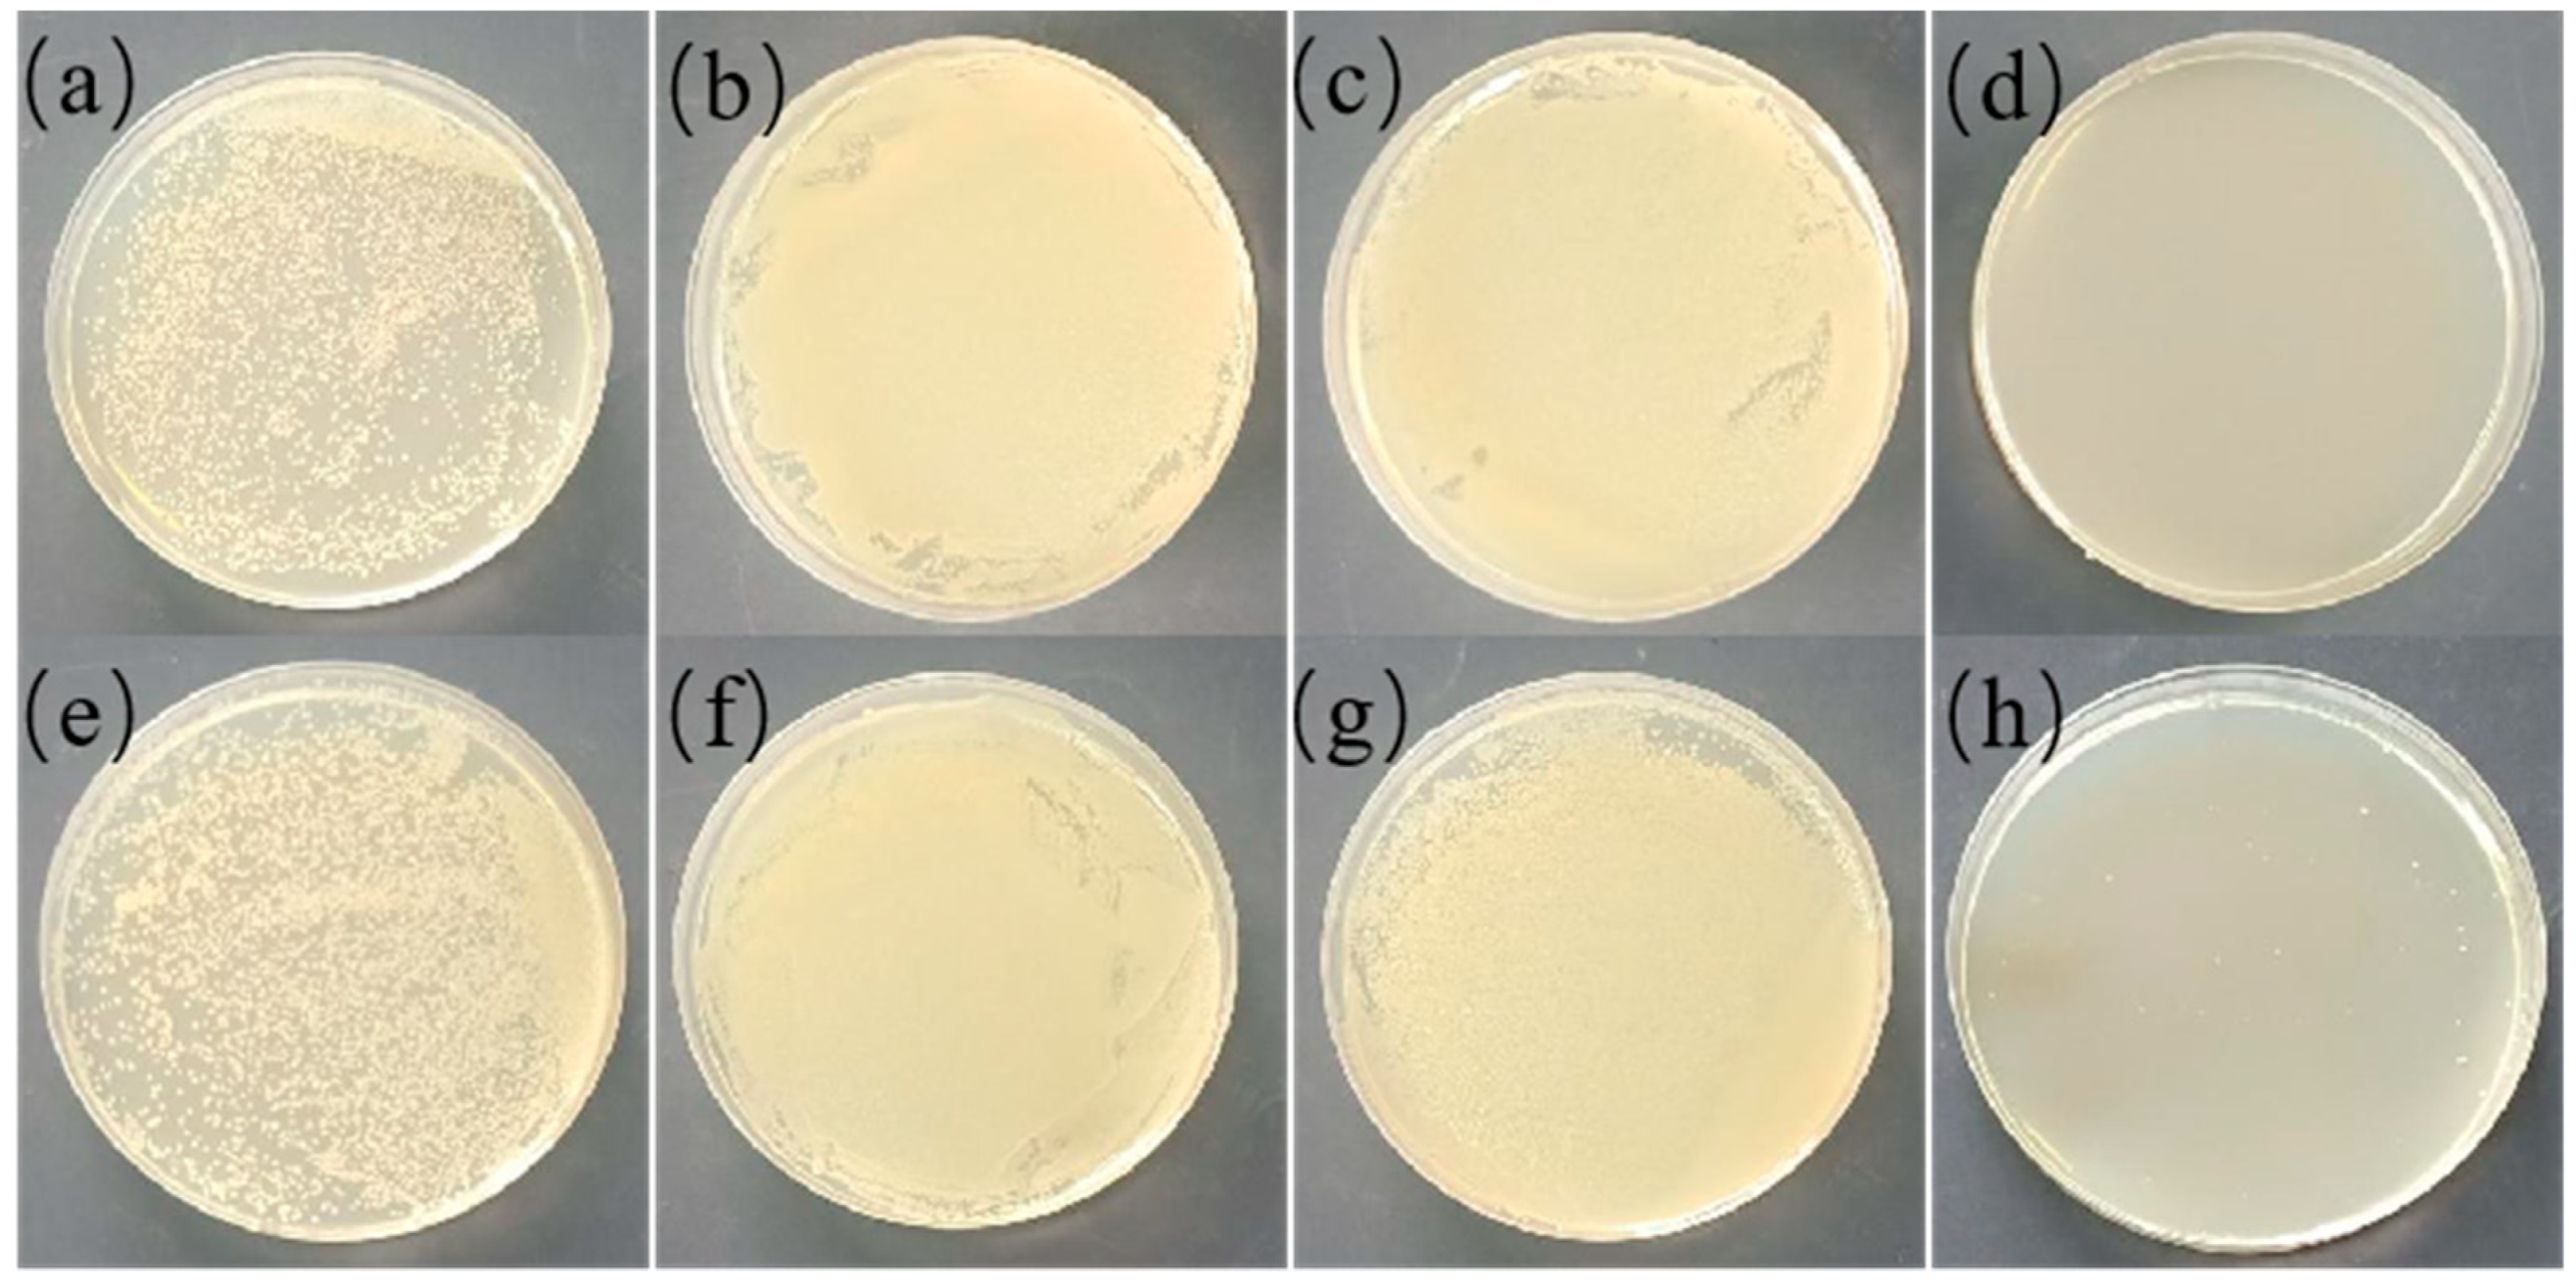
Polymers 13 02336 g011 550

Preparation and Performance Evaluation of Antibacterial Melt-Spun Polyurethane Fiber Loaded with Berberine Hydrochloride
Abstract
:1. Introduction
2. Materials and Methods
2.1. Materials
2.2. Minimum Inhibitory Concentration (MIC) of BCH on E. coli and S. aureus
2.3. Time-Killing Performance of BCH on E. coli and S. aureus
2.4. The Effect of BCH on the Respiratory Chain Dehydrogenase Activity of E. coli and S. aureus
2.5. The Influence of BCH on the Morphology of E. coli and S. aureus
2.6. The Effect of BCH on the Release of E. coli Intracellular Macromolecules
2.7. Preparation and Coating Treatment of Melt-Spun Polyurethane Fiber
2.8. Characterizations of Fibers
2.9. Antibacterial Property of Fibers
3. Results and Discussion
3.1. The MICs and Time-Killing Effect of BCH on E. coli and S. aureus
3.2. Measurement of Respiratory Chain Dehydrogenase Activity
3.3. The Influence of BCH on the Morphology of Bacteria
3.4. The Effect of BCH on the Release of Intracellular Macromolecules in E. coli
3.5. Fiber Morphologies
3.6. Surface Wettability Investigation
3.7. Thermogravimetric Analysis
3.8. Mechanical Properties
3.9. Antibacterial Properties of the Fibers
4. Conclusions
Author Contributions
Funding
Institutional Review Board Statement
Informed Consent Statement
Data Availability Statement
Conflicts of Interest
References
- Chen, W.Y.; Chang, H.Y.; Lu, J.K.; Huang, Y.C.; Harroun, S.G.; Tseng, Y.T.; Li, Y.J.; Huang, C.C.; Chang, H.T. Self-Assembly of Antimicrobial Peptides on Gold Nanodots: Against Multidrug-Resistant Bacteria and Wound-Healing Application. Adv. Funct. Mater. 2015, 25, 7189–7199. [Google Scholar] [CrossRef]
- Zhang, X.X.; Yan, Y.D.; Xu, J.; Shao, X.J.; Zhang, X.L.; Tao, Y.Z.; Ji, W.; Chen, Z.R. Role of preceding viral or Mycoplasma pneumoniae infection in invasive bacterial diseases in Chinese children. Int. J. Clin. Exp. Med. 2018, 11, 4680–4687. [Google Scholar]
- Jusot, J.F.; Neill, D.R.; Waters, E.M.; Bangert, M.; Collins, M.; Moreno, L.B.; Lawan, K.G.; Moussa, M.; Dearing, E.; Everett, D.B.; et al. Airborne dust and high temperatures are risk factors for invasive bacterial disease. J. Allergy Clin. Immun. 2017, 139, 977–986.e2. [Google Scholar] [CrossRef] [Green Version]
- Luo, H.; Gong, D.K.; Yang, F.; Zeng, R.; Zhang, Y.; Tan, L. Preparation and characterization of polyurethane-Rheum rhabarbarum-zirconium phosphate composite fiber with antibacterial and antioxidant properties. Mater. Express 2021, 11, 123–132. [Google Scholar] [CrossRef]
- Qiu, Q.H.; Chen, S.Y.; Li, Y.P.; Yang, Y.C.; Zhang, H.N.; Quan, Z.Z.; Qin, X.H.; Wang, R.W.; Yu, J.Y. Functional nanofibers embedded into textiles for durable antibacterial properties. Chem. Eng. J. 2020, 384, 123241. [Google Scholar] [CrossRef]
- Masood, R.; Khubaib, M.A.; Hussain, T.; Raza, Z.A. Silver-containing polysaccharide based tricomponent antibacterial fibres for wound care applications. J. Wound Care 2021, 30, 81–88. [Google Scholar] [CrossRef] [PubMed]
- Qin, M.; Liu, D.Q.; Dai, Z.; Meng, X.; Liu, G.S.; Liu, H.; Huang, X.W.; Yan, X.; Chen, S.J. One Step Fabrication and Application of Antibacterial Electrospun Zein/Cinnamon Oil Membrane Wound Dressing via In situ Electrospinning Process. Chem. Res. Chin. Univ. 2021, 26, 464–469. [Google Scholar]
- Yin, X.Q.; Zhang, J.; Xu, J.Z.; Tian, M.; Li, L.Y.; Tan, L.; Li, Z.M. Fast-acting and highly rechargeable antibacterial composite nanofibrous membrane for protective applications. Compos. Sci. Technol. 2021, 202, 108574. [Google Scholar] [CrossRef]
- Yue, Y.P.; Gong, X.B.; Jiao, W.L.; Li, Y.; Yin, X.; Si, Y.; Yu, J.Y.; Ding, B. In-situ electrospinning of thymol-loaded polyurethane fibrous membranes for waterproof, breathable, and antibacterial wound dressing application. J. Colloid Interface Sci. 2021, 592, 310–318. [Google Scholar] [CrossRef]
- Soo, J.Z.; Chai, L.C.; Ang, B.C.; Ong, B.H. Enhancing the Antibacterial Performance of Titanium Dioxide Nanofibers by Coating with Silver Nanoparticles. ACS Appl. Nano Mater. 2020, 3, 5743–5751. [Google Scholar] [CrossRef]
- Llorens, E.; Calderon, S.; del Valle, L.J.; Puiggali, J. Polybiguanide (PHMB) loaded in PLA scaffolds displaying high hydrophobic, biocompatibility and antibacterial properties. Mater. Sci. Eng. C-Mater. 2015, 50, 74–84. [Google Scholar] [CrossRef]
- AshaRani, P.V.; Mun, G.L.K.; Hande, M.P.; Valiyaveettil, S. Cytotoxicity and Genotoxicity of Silver Nanoparticles in Human Cells. ACS Nano 2009, 3, 279–290. [Google Scholar] [CrossRef] [PubMed]
- Wen, Y.; Zhao, R.F.; Yin, X.Q.; Shi, Y.D.; Fan, H.J.; Zhou, Y.; Tan, L. Antibacterial and Antioxidant Composite Fiber Prepared from Polyurethane and Polyacrylonitrile Containing Tea Polyphenols. Fiber Polym. 2020, 21, 103–110. [Google Scholar] [CrossRef]
- Yin, X.Q.; Tan, P.F.; Luo, H.; Lan, J.W.; Shi, Y.D.; Zhang, Y.; Fan, H.J.; Tan, L. Study on the release behaviors of berberine hydrochloride based on sandwich nanostructure and shape memory effect. Mater. Sci. Eng. C-Mater. 2020, 109, 110541. [Google Scholar] [CrossRef] [PubMed]
- Zhou, W.C.; Tan, P.F.; Chen, X.H.; Cen, Y.; You, C.; Tan, L.; Li, H.; Tian, M. Berberine-Incorporated Shape Memory Fiber Applied as a Novel Surgical Suture. Front. Pharmacol. 2020, 10, 1506. [Google Scholar] [CrossRef] [PubMed] [Green Version]
- Tang, J.M.; Zhao, R.F.; Yin, X.Q.; Wen, Y.; Shi, Y.D.; Zhu, P.X.; Chen, Z.; Zeng, R.; Tan, L. Programmable Release of Berberine Chloride Hydrate from Shape Memory Fibers Prepared from Core-Sheath Wet-Spinning Technology. J. Biomed. Nanotechnol. 2019, 15, 1432–1442. [Google Scholar] [CrossRef] [PubMed]
- Zhang, X.J.; Dai, K.L.; Liu, C.Y.; Hu, H.F.; Luo, F.L.; Qi, Q.F.; Wang, L.; Ye, F.; Jin, J.; Tang, J.; et al. Berberine-Coated Biomimetic Composite Microspheres for Simultaneously Hemostatic and Antibacterial Performance. Polymers 2021, 13, 360. [Google Scholar] [CrossRef]
- Wang, H.F.; Liu, X.; Christiansen, D.E.; Fattahpour, S.; Wang, K.; Song, H.Q.; Mehraeen, S.; Cheng, G. Thermoplastic polyurethane with controllable degradation and critical anti-fouling properties. Biomater. Sci. 2021, 9, 1381–1396. [Google Scholar] [CrossRef] [PubMed]
- Guo, Y.F.; Zhang, H.F.; Duan, S.; Ding, X.K.; Hu, Y.; Ding, X.J.; Xu, F.J. Bulk Modification of Thermoplastic Polyurethanes for Self-Sterilization of Trachea Intubation. Macromol. Biosci. 2021, 21, 2000318. [Google Scholar] [CrossRef] [PubMed]
- Pant, B.; Park, M.; Ojha, G.P.; Kim, D.U.; Kim, H.Y.; Park, S.J. Electrospun salicylic acid/polyurethane composite nanofibers for biomedical applications. Int. J. Polym. Mater. 2018, 67, 739–744. [Google Scholar] [CrossRef]
- Li, A.H.; Sun, M.; Ma, Z.D.; Chen, S.F.; Zhu, G.Y.; Zhang, Y.; Wang, W. Anticorrosion performance of polyvinyl butyral composite coatings improved by polyaniline-multiwalled carbon nanotubes/poly(methylhydrosiloxane). Thin Solid Films 2020, 712, 138347. [Google Scholar] [CrossRef]
- Mahmoudian, M.R.; Alias, Y.; Basirun, W.J. Effect of narrow diameter polyaniline nanotubes and nanofibers in polyvinyl butyral coating on corrosion protective performance of mild steel. Prog. Org. Coat. 2012, 75, 301–308. [Google Scholar] [CrossRef]
- Negishi, H.; Takehiro, Y.; Akira, E. Preparation and characterization of mesoporous silica-polyvinyl butyral hybrid coatings by electrophoretic deposition. Microporous Mesoporous Mater. 2020, 292, 109710. [Google Scholar] [CrossRef]
- Roszol, L.; Lawson, T.; Koncz, V.; Noszticzius, Z.; Wittmann, M.; Sarkadi, T.; Koppa, P. Micropatterned Polyvinyl Butyral Membrane for Acid-Base Diodes. J. Phys. Chem. B 2010, 114, 13718–13725. [Google Scholar] [CrossRef] [PubMed]
- Liang, S.; Dang, Q.; Liu, C.; Zhang, Y.; Wang, Y.; Zhu, W.; Chang, G.; Sun, H.; Cha, D.; Fan, B. Characterization and antibacterial mechanism of poly(aminoethyl) modified chitin synthesized via a facile one-step pathway. Carbohydr. Polym. 2018, 195, 275–287. [Google Scholar] [CrossRef]
- Li, Z.H.; Cai, M.; Liu, Y.S.; Sun, P.L.; Luo, S.L. Antibacterial Activity and Mechanisms of Essential Oil from Citrus medica L. var. sarcodactylis. Molecules 2019, 24, 1577. [Google Scholar] [CrossRef] [Green Version]
- Li, W.R.; Xie, X.B.; Shi, Q.S.; Zeng, H.Y.; Ou-Yang, Y.S.; Chen, Y.B. Antibacterial activity and mechanism of silver nanoparticles on Escherichia coli. Appl. Microbiol. Biotechnol. 2010, 85, 1115–1122. [Google Scholar] [CrossRef]
- Lv, F.; Liang, H.; Yuan, Q.P.; Li, C.F. In vitro antimicrobial effects and mechanism of action of selected plant essential oil combinations against four food-related microorganisms. Food Res. Int. 2011, 44, 3057–3064. [Google Scholar] [CrossRef]

| Section | Zone-1 | Zone-2 | Zone-3 | Zone-4 |
|---|---|---|---|---|
| Temperature/°C | 120 | 190 | 195 | 195 |
| Section | Extrusion head | Metering pumps | Pump base | Melt pipeline |
| Speed | 200 m/min | 205 m/min | 205 m/min | 205 m/min |
| Temperature/°C | 200 | 195 | 195 | 195 |
| Section | Metering Pump A | Metering Pump B | Oil Pump | Roller 1 |
|---|---|---|---|---|
| Speed | 15 r/min | 15 r/min | 12 r/min | 200 m/min |
| Section | Roller 2 | Roller 3 | Roller 4 | Winder |
| Speed | 200 m/min | 205 m/min | 205 m/min | 200 m/min |
| Strains | Concentrations of Berberine Hydrochloride (μg/mL) | |||||
|---|---|---|---|---|---|---|
| 6.25 | 12.5 | 25 | 50 | 100 | ||
| Inhibition ratio (%) | E. coli | 28.2609 | 63.7681 | 92.0290 | 99.9997 | 100 |
| S. aureus | 93.6800 | 96.8400 | 99.9973 | 100 | 100 | |
| Fiber Type | Linear Density (Tex) | Breaking Strength (cN/Tex) | Elongation at Break (%) |
|---|---|---|---|
| TPU | 34.90 ± 1.25 | 12.13 ± 0.40 | 262.47 ± 6.99 |
| TPU/PVB | 53.15 ± 0.54 | 5.19 ± 0.27 | 366.21 ± 19.88 |
| TPU/PVB/BCH | 54.59 ± 0.44 | 5.81 ± 0.29 | 403.06 ± 17.98 |
Publisher’s Note: MDPI stays neutral with regard to jurisdictional claims in published maps and institutional affiliations. |
© 2021 by the authors. Licensee MDPI, Basel, Switzerland. This article is an open access article distributed under the terms and conditions of the Creative Commons Attribution (CC BY) license (https://creativecommons.org/licenses/by/4.0/).
Share and Cite
Zhao, R.; Tan, P.; Han, Y.; Yang, F.; Shi, Y.; Zhu, P.; Tan, L. Preparation and Performance Evaluation of Antibacterial Melt-Spun Polyurethane Fiber Loaded with Berberine Hydrochloride. Polymers 2021, 13, 2336. https://doi.org/10.3390/polym13142336
Zhao R, Tan P, Han Y, Yang F, Shi Y, Zhu P, Tan L. Preparation and Performance Evaluation of Antibacterial Melt-Spun Polyurethane Fiber Loaded with Berberine Hydrochloride. Polymers. 2021; 13(14):2336. https://doi.org/10.3390/polym13142336
Chicago/Turabian StyleZhao, Ruifang, Pengfei Tan, Yanting Han, Feng Yang, Yidong Shi, Puxin Zhu, and Lin Tan. 2021. "Preparation and Performance Evaluation of Antibacterial Melt-Spun Polyurethane Fiber Loaded with Berberine Hydrochloride" Polymers 13, no. 14: 2336. https://doi.org/10.3390/polym13142336
APA StyleZhao, R., Tan, P., Han, Y., Yang, F., Shi, Y., Zhu, P., & Tan, L. (2021). Preparation and Performance Evaluation of Antibacterial Melt-Spun Polyurethane Fiber Loaded with Berberine Hydrochloride. Polymers, 13(14), 2336. https://doi.org/10.3390/polym13142336

